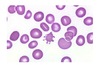

RBCs Flashcards
1
Q

A
- dark proerythroblast with loosely arranged nuclear chromatin
- two polychromatic erythroblasts
- Metamyelocyte
2
Q

A
Proerythroblast
3
Q

A
- Two basophilic erythroblasts
- Polychromatic erythroblast
4
Q

A
- Polychromatic erythroblast
- Orthochromatic erythroblast (normoblast)
5
Q

A
- Lymphocyte
- Orthochromatic erythroblast
- Polychromatic erythrocyte
6
Q

A
- Schistocyte (Fragmentocyte)
- Echinocyte
7
Q

A
- Schistocytes (Fragmentocyte)
- Target cell
8
Q

A
- Native sickle cell (drepanocyte)
- Target cell
9
Q

A
Stomatocytes
10
Q

A
- Normal erythrocyte
- Macrocyte
- Ovoid megalocyte
- Hypersegmented neutrophil
11
Q

A
Basophilic stippling
12
Q

A
Erythrocyte with Howell–Jolly bodies (arrow)
13
Q

A
Elliptocytes (ovalocytes)
14
Q

A
Spherocytes
15
Q

A
Acanthocytes or “burr cells”
16
Q

A
Knizocytes (triconcave erythrocytes)
17
Q

A
Schistocytes (fragmentocytes)
18
Q

A
Reticulocytes
19
Q

A
Pappenheimer bodies
20
Q

A
Degmacytes
21
Q

A
Hemoglobin C crystals
22
Q
A
Acanthocyte